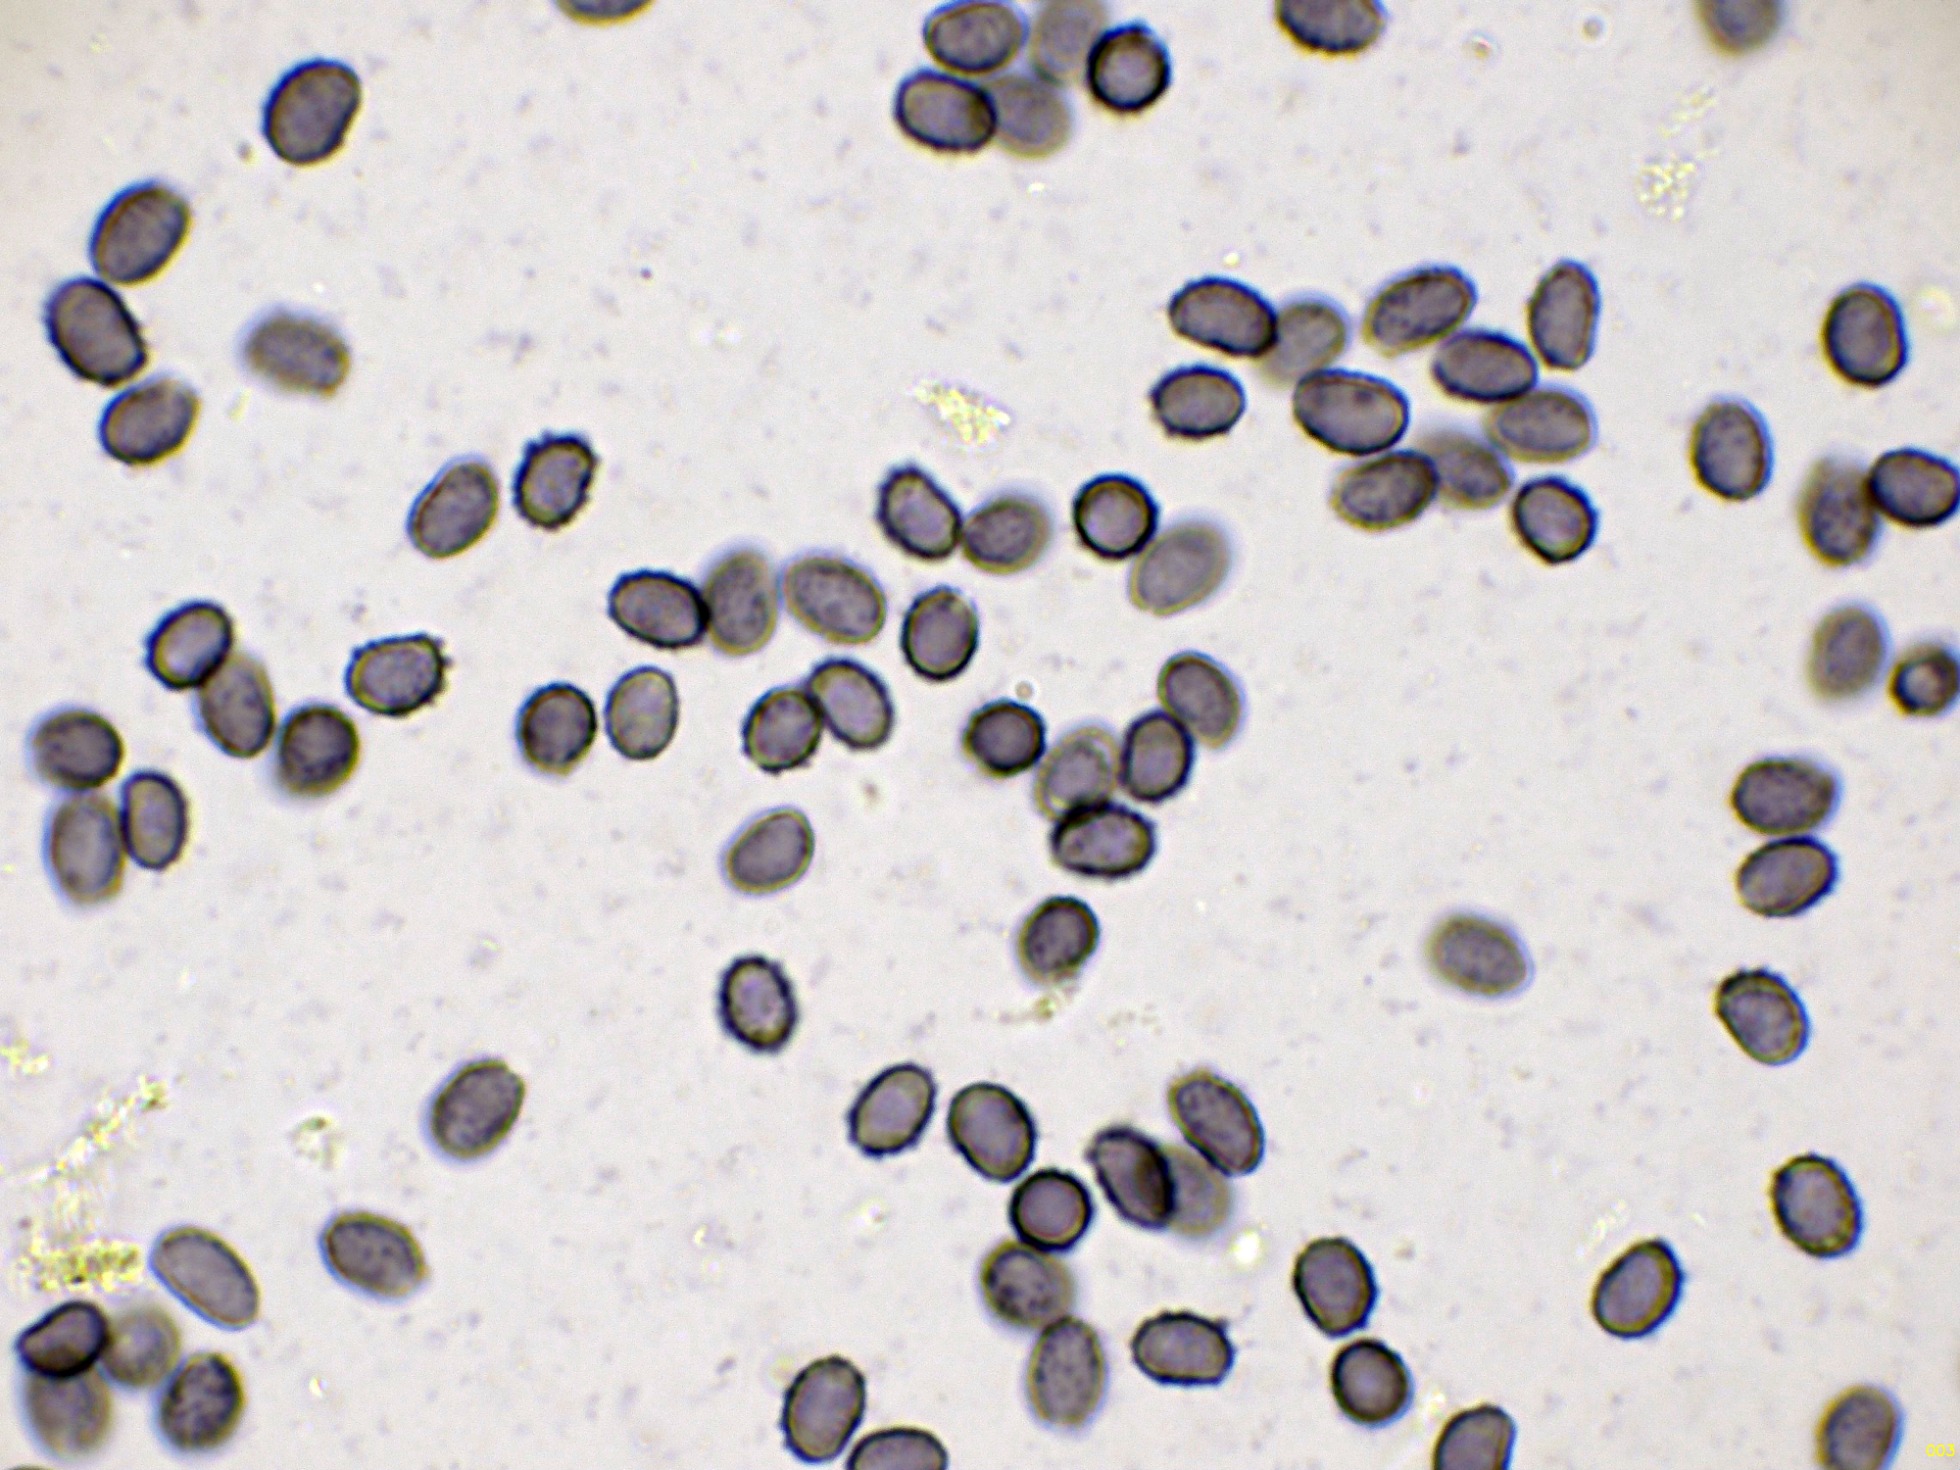

- Foro
- Foros sobre Micología de fungipedia
- Microscopía
- Un resto de la recogida de muestras del 5 de octubre: 2ª entrega.
 Un resto de la recogida de muestras del 5 de octubre: 2ª entrega.
Un resto de la recogida de muestras del 5 de octubre: 2ª entrega.
- Josep Torres
-
 Autor del tema
Autor del tema
- Fuera de línea
- Moderador
-

Menos
Más
- Mensajes: 8746
- Gracias recibidas: 8379
5 meses 1 semana antes - 5 meses 1 semana antes #110709
por Josep Torres
Hola.
Seguimos con unas cuantas más de lo que pude encontrar el 5 de octubre pasado, la primera es una que hasta la fecha no había tenido el placer de estudiar, el Leucopaxillus compactus:
Detalle de las láminas adnatas, de color amarillo y muchas de ellas bifurcadas:
Sección con un pie muy robusto y bulboso:
Las hifas de la suprapellis en agua:
Las hifas de la subpellis en el mismo medio:
Una imágen con las medidas en anchura de las hifas de la pileipellis:
Las hifas del estípite sin caulocistidios observados:
Las hifas de la trama laminar, con gruesas fíbulas:
Arista laminar en solución de Rojo Congo:
La arista laminar está tapizada de numerosos elementos terminales cilíndricos, bifurcados, algunos digitados y hasta incluso ramificados.
La arista laminar en Reactivo de Melzer:
Los basidios de la cara laminar en solución de Rojo Congo, con unas medidas de (27.1) 30.6 - 38.2 (38.5) × 7.1 - 9 (9.1) µm.:
Las esporas en Reactivo de Melzer:
Y las esporas en agua:
Estas esporas obtenidas por esporulación natural y en agua con unas medidas de:
(6.4) 6.9 - 7.9 (8.1) × (4.8) 5 - 5.6 (5.9) µm
Q = (1.2) 1.3 - 1.5 (1.6) ; N = 40
Me = 7.4 × 5.3 µm ; Qe = 1.4
Seguimos con un Corticial, con abundantes gloeocistidios, el Gloeocistidiellum luridum:
Superficie del basidioma a 20 aumentos:
Las hifas subhimeniales fibuladas en solución de amoníaco:
Los gloeocistidios en amoníaco:
Gloeocistidios en Reactivo de Melzer:
Gloeocistidios en Sulfovainillina:
Superficie del himenio en solución de Rojo Congo:
Los basidios en amoníaco:
Los basidios en Reactivo de Melzer:
Las esporas en Reactivo de Melzer, inamiloides:
Y las esporas en agua:
Estas esporas obtenidas por esporulación natural y en agua con unas medidas de:
(8.3) 9 - 10.3 (11) × (5.1) 5.4 - 5.8 (5.9) µm
Q = (1.5) 1.6 - 1.9 (2) ; N = 30
Me = 9.6 × 5.5 µm ; Qe = 1.7
Compartiendo espacio con la anterior y brotando encima de ella, tenemos unos apotecios de la abundante Rhizodiscina lygniota:
Los apotecios a 20 aumentos:
Solo he tenido que observar algunos ascos para poder confirmar con seguridad la especie.
Los ascos a 1000 aumentos:
Seguimos.....................................
Seguimos con unas cuantas más de lo que pude encontrar el 5 de octubre pasado, la primera es una que hasta la fecha no había tenido el placer de estudiar, el Leucopaxillus compactus:
Detalle de las láminas adnatas, de color amarillo y muchas de ellas bifurcadas:
Sección con un pie muy robusto y bulboso:
Las hifas de la suprapellis en agua:
Las hifas de la subpellis en el mismo medio:
Una imágen con las medidas en anchura de las hifas de la pileipellis:
Las hifas del estípite sin caulocistidios observados:
Las hifas de la trama laminar, con gruesas fíbulas:
Arista laminar en solución de Rojo Congo:
La arista laminar está tapizada de numerosos elementos terminales cilíndricos, bifurcados, algunos digitados y hasta incluso ramificados.
La arista laminar en Reactivo de Melzer:
Los basidios de la cara laminar en solución de Rojo Congo, con unas medidas de (27.1) 30.6 - 38.2 (38.5) × 7.1 - 9 (9.1) µm.:
Las esporas en Reactivo de Melzer:
Y las esporas en agua:
Estas esporas obtenidas por esporulación natural y en agua con unas medidas de:
(6.4) 6.9 - 7.9 (8.1) × (4.8) 5 - 5.6 (5.9) µm
Q = (1.2) 1.3 - 1.5 (1.6) ; N = 40
Me = 7.4 × 5.3 µm ; Qe = 1.4
Seguimos con un Corticial, con abundantes gloeocistidios, el Gloeocistidiellum luridum:
Superficie del basidioma a 20 aumentos:
Las hifas subhimeniales fibuladas en solución de amoníaco:
Los gloeocistidios en amoníaco:
Gloeocistidios en Reactivo de Melzer:
Gloeocistidios en Sulfovainillina:
Superficie del himenio en solución de Rojo Congo:
Los basidios en amoníaco:
Los basidios en Reactivo de Melzer:
Las esporas en Reactivo de Melzer, inamiloides:
Y las esporas en agua:
Estas esporas obtenidas por esporulación natural y en agua con unas medidas de:
(8.3) 9 - 10.3 (11) × (5.1) 5.4 - 5.8 (5.9) µm
Q = (1.5) 1.6 - 1.9 (2) ; N = 30
Me = 9.6 × 5.5 µm ; Qe = 1.7
Compartiendo espacio con la anterior y brotando encima de ella, tenemos unos apotecios de la abundante Rhizodiscina lygniota:
Los apotecios a 20 aumentos:
Solo he tenido que observar algunos ascos para poder confirmar con seguridad la especie.
Los ascos a 1000 aumentos:
Seguimos.....................................
Última Edición: 5 meses 1 semana antes por Josep Torres.
Por favor, Identificarse para unirse a la conversación.
- Josep Torres
-
 Autor del tema
Autor del tema
- Fuera de línea
- Moderador
-

Menos
Más
- Mensajes: 8746
- Gracias recibidas: 8379
5 meses 1 semana antes - 5 meses 1 semana antes #110710
por Josep Torres
Respuesta de Josep Torres sobre el tema Un resto de la recogida de muestras del 5 de octubre: 2ª entrega.
Seguimos con otro Corticial, muy parecido tanto en el aspecto macro como a nivel microscópico al anterior pero sin gloeocistidios, sobre un tronco tumbado de Pinus sylvestris, probablemente el Hypochnicium bombycinum:
Superficie del basidioma a 20 aumentos:
Las hifas subhimeniales en Reactivo de Melzer, fibuladas:
Los basidios en solución de Rojo Congo, con unas medidas de (41.3) 42.3 - 48.9 (60.9) × (5.5) 7.1 - 8.6 (9.1) µm.:
Los basidios en Reactivo de Melzer:
Las esporas en reactivo de Melzer, inamiloides:
Y las esporas en agua:
Estas esporas obtenidas por esporulación natural y en agua con unas medidas de:
(8.8) 9.7 - 11.4 (12.5) × (5.3) 5.4 - 6.2 (6.5) µm
Q = (1.6) 1.7 - 1.9 (2) ; N = 30
Me = 10.5 × 5.9 µm ; Qe = 1.8
Añado un dibujo de Ryvarden con la microscopía de la especie:
Sobre un tocón de roble tenemos la Mycena polygramma:
Hifas de la suprapellis en agua:
Hifas de la subpellis en agua:
Los queilocistidios en solución de Rojo Congo diluido:
Los queilocistidios en solución de amoníaco (NH4OH):
Los basidios en solución de Rojo Congo:
Los basidios en amoníaco:
Las esporas en Reactivo de Melzer, amiloides:
Y las esporas en agua:
Estas esporas obtenidas por esporulación natural y en agua con unas medidas de:
(9.9) 10 - 11.4 (11.6) × (6.5) 7 - 8.2 (8.3) µm
Q = (1.3) 1.35 - 1.5 (1.7) ; N = 24
Me = 10.6 × 7.5 µm ; Qe = 1.4
Para terminar con esta entrega tenemos una Russula, de la sección Nigricantinae, probablemente Russula anthracina, aunque con las Russulas nunca se sabe:
Detalle de la carne poco ennegreciente al corte:
Comportamiento frente al Sulfato ferroso, con tonos anaranjados en láminas:
Hifas de la suprapellis en agua:
La subpellis en agua, con abundantes esferocistos:
La arista laminar en solución de Rojo Congo:
La arista laminar en Reactivo de Melzer:
Los basidios de la cara laminar en solución de Rojo Congo, con unas medidas de (38.1) 39.2 - 51.9 (53.2) × (7.1) 7.4 - 9.6 (10.5) µm.:
Los basidios en Reactivo de Melzer:
Las esporas en Reactivo de Melzer:
Y por último las mismas esporas vistas en distinto plano para poder observar mejor su ornamentación:
Estas esporas obtenidas por esporulación natural con unas medidas de:
(7.7) 8.5 - 9.7 (10) × (6.9) 7.1 - 8.1 (8.4) µm
Q = (1) 1.1 - 1.26 (1.3) ; N = 32
Me = 9 × 7.7 µm ; Qe = 1.2
Saludos.
Superficie del basidioma a 20 aumentos:
Las hifas subhimeniales en Reactivo de Melzer, fibuladas:
Los basidios en solución de Rojo Congo, con unas medidas de (41.3) 42.3 - 48.9 (60.9) × (5.5) 7.1 - 8.6 (9.1) µm.:
Los basidios en Reactivo de Melzer:
Las esporas en reactivo de Melzer, inamiloides:
Y las esporas en agua:
Estas esporas obtenidas por esporulación natural y en agua con unas medidas de:
(8.8) 9.7 - 11.4 (12.5) × (5.3) 5.4 - 6.2 (6.5) µm
Q = (1.6) 1.7 - 1.9 (2) ; N = 30
Me = 10.5 × 5.9 µm ; Qe = 1.8
Añado un dibujo de Ryvarden con la microscopía de la especie:
Sobre un tocón de roble tenemos la Mycena polygramma:
Hifas de la suprapellis en agua:
Hifas de la subpellis en agua:
Los queilocistidios en solución de Rojo Congo diluido:
Los queilocistidios en solución de amoníaco (NH4OH):
Los basidios en solución de Rojo Congo:
Los basidios en amoníaco:
Las esporas en Reactivo de Melzer, amiloides:
Y las esporas en agua:
Estas esporas obtenidas por esporulación natural y en agua con unas medidas de:
(9.9) 10 - 11.4 (11.6) × (6.5) 7 - 8.2 (8.3) µm
Q = (1.3) 1.35 - 1.5 (1.7) ; N = 24
Me = 10.6 × 7.5 µm ; Qe = 1.4
Para terminar con esta entrega tenemos una Russula, de la sección Nigricantinae, probablemente Russula anthracina, aunque con las Russulas nunca se sabe:
Detalle de la carne poco ennegreciente al corte:
Comportamiento frente al Sulfato ferroso, con tonos anaranjados en láminas:
Hifas de la suprapellis en agua:
La subpellis en agua, con abundantes esferocistos:
La arista laminar en solución de Rojo Congo:
La arista laminar en Reactivo de Melzer:
Los basidios de la cara laminar en solución de Rojo Congo, con unas medidas de (38.1) 39.2 - 51.9 (53.2) × (7.1) 7.4 - 9.6 (10.5) µm.:
Los basidios en Reactivo de Melzer:
Las esporas en Reactivo de Melzer:
Y por último las mismas esporas vistas en distinto plano para poder observar mejor su ornamentación:
Estas esporas obtenidas por esporulación natural con unas medidas de:
(7.7) 8.5 - 9.7 (10) × (6.9) 7.1 - 8.1 (8.4) µm
Q = (1) 1.1 - 1.26 (1.3) ; N = 32
Me = 9 × 7.7 µm ; Qe = 1.2
Saludos.
Adjuntos:
Última Edición: 5 meses 1 semana antes por Josep Torres. Razón: Poner un nombre en negrita
Por favor, Identificarse para unirse a la conversación.
- Foro
- Foros sobre Micología de fungipedia
- Microscopía
- Un resto de la recogida de muestras del 5 de octubre: 2ª entrega.
Tiempo de carga de la página: 1.326 segundos

Foro de micología